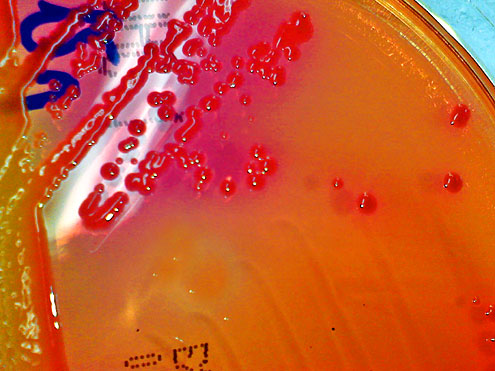

Pandemia de gripe A, epidemia de cólera no Haiti, surto de catapora e de meningite no Brasil, nova bactéria KCP no Distrito Federal. Notícias como estas estão cada vez mais presentes na imprensa brasileira e criam certo clima de pânico entre a população.
No entanto, de acordo com Jaime Rocha, infectologista do Frischmann Aisengart/DASA, não há motivos para preocupações exageradas e que a população precisa entender a diferença entre epidemia, surto, pandemia e endemia.
De acordo com o infectologista, o volume de proliferações e surgimentos de doenças infecciosas que enfrentamos hoje é considerado normal e controlável. “O que temos é uma divulgação cada vez maior e mais rápida dessas doenças, pelos meios de comunicação físicos e virtuais”, atesta, salientando que esse “boom” de notícias, aliado ao desconhecimento da população, ajuda a gerar o pânico, fazendo com que vivêssemos uma espécie de fenômeno social da epidemia.
Diferenças
Quanto à diferença entre os termos, o médico explica que a endemia é uma doença que se manifesta em determinada região com índices estáveis de incidência e de prevalência (casos novos e número total de casos).
Ou seja, é uma doença habitual daquela região, não se espalhando efetivamente para outras comunidades. Um exemplo é a malária, que é endêmica na região Amazônica e que não ocorre em outras regiões. Essas doenças endêmicas podem ser adquiridas por viajantes para essas regiões.
Já as epidemias ou os surtos, de acordo com o especialista, acontecem quando uma doença surge em populações não afetadas anteriormente ou quando ocorre um grande aumento no número total de casos de determinada região ou localidades específicas, como países, estados, cidades ou bairros.
O termo acaba sendo usado pela mídia geralmente em situações em que a doença envolve um grande número de pessoas e atinge uma larga área geográfica.
Os surtos são ligados às doenças infecciosas e transmissíveis e têm potencial para se espalhar mais ou menos rapidamente entre as pessoas de outras regiões contíguas.
Isso poderá ocorrer por causa de um grande desequilíbrio (mutação) do agente causal ou transmissor, pelo surgimento de um novo agente (desconhecido) ou por questões ambientais.
Um exemplo é a epidemia de cólera no Haiti. “Com o tempo e um ambiente estável a ocorrência da doença passa de epidêmica para endêmica e, depois, para esporádica, caso consiga ser controlada”, afirma o infectologista.
Pandemia
Rocha explica que a pandemia, de uma forma simplificada, é uma epidemia que atinge grandes proporções, podendo se espalhar por um ou mais continentes ou pelo mundo.
O termo pandemia não está necessariamente associado com o número de mortes. De acordo com a Organização Mundial da Saúde (OMS), são condições favorecedoras ao surgimento de uma pandemia: aparecimento de uma nova doença à população, quando o agente transmissor infecta os humanos, quando o agente se dissemina facilmente e sustentavelmente entre humanos.
Nesse sentido, os critérios de definição de uma pandemia também incluem a doença ou condição que, além de se espalhar ou matar um grande número de pessoas, deve ser infecciosa. Alguns exemplos são Aids, tuberculose e gripe A, entre outras.
O infectologista lembra que esses casos só valem para doenças infecciosas. “Por isso o câncer, apesar de ser responsável por inúmeras mortes, não é considerado uma pandemia porque n&at,ilde;o uma é doença transmissível”, finaliza.
Cuidados para sempre
Doentes – Evitar o contato direto, entre eles, beijos e apertos de mão, com pessoas doentes. Se possível, não frequentar ambientes fechados, ou no mínimo, manter distância.
Roupa – A roupa, em geral, não é um veículo para transmissão de vírus. O vírus da gripe, por exemplo, é transmitida pelo ar. Portanto, apenas profissionais que atuam em hospitais devem tomar cuidado com o jaleco quando entram em ambientes controlados, como o centro cirúrgico, por exemplo.
Ventilação – A concentração de vírus e bactérias, em ambientes fechados, facilita a transmissão de doenças. A ventilação é a solução. Abrir janelas por algumas horas ao dia e manter limpo o sistema de ar condicionado ajudam muito.
Vacina – Crianças e idosos devem recorrer às vacinas, em especial, contra gripe, pneumonia e hepatite B. As consequências das doenças nessas duas populações são mais perigosas, portanto a prevenção, por meio da vacina, é uma importante aliada.
Hepatite – Se a pessoa não tiver certeza se tomou a vacina contra a hepatite, deve procurar um médico para fazer o exame de detecção da doença. Além de tomar medidas para tratamento, a pessoa poderá evitar sua transmissão para outros sem saber.
Hospital e clínicas de saúde – Pessoas que vão ao hospital para trabalhar ou visitar doentes devem lavar as mãos, dentro do hospital, ao entrar e ao sair.
Mãos – Lavar as mãos o maior número de vezes ao dia é o procedimento mais simples e o mais importante. Com as mãos, as pessoas tocam maçaneta, corrimão, olhos, boca e muito mais, o que facilita levar vírus e bactérias de um lugar para outro.
Fonte: Abrão Cury, Sociedade Brasileira de Clínica Médica.
Antibióticos demais
Os antibióticos vendidos nas farmácias e drogarias do país só poderão ser entregues ao consumidor mediante receita de controle especial em duas vias. A primeira via ficará retida no estabelecimento farmacêutico e a segunda deverá ser devolvida ao paciente com carimbo para comprovar o atendimento.
A retenção das receitas dos antibióticos será obrigatória a partir de 28 de novembro de 2010. A partir deste dia, os prescritores devem atentar para a necessidade de entregar, de forma legível e sem rasuras, duas vias do receituário aos pacientes.